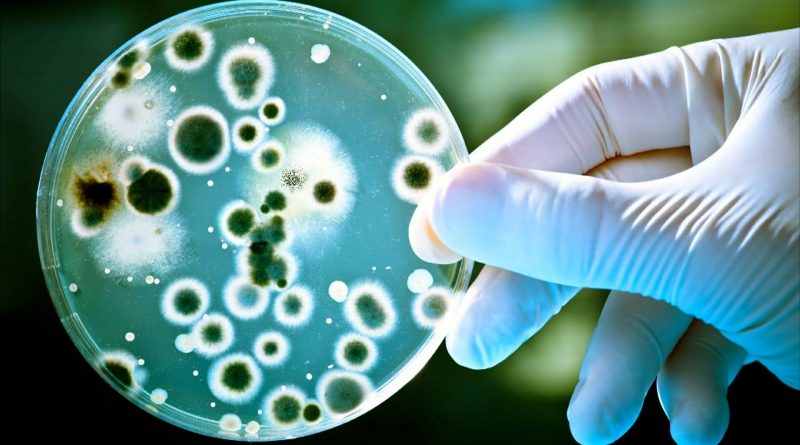

Más de 3.000 personas resultaron infectadas de brucelosis por una fuga en China
Investigadores revelaron que más de 3.000 personas se infectaron con brucelosis en la localidad china de Lanzhou. De acuerdo con medios locales, el hecho ocurrió el pasado 2019, luego de una fuga bacterial en una fábrica biofarmacéutica.
De acuerdo con la Comisión de Salud local, de 22.000 personas analizadas, 3.245 confirmaron el contagio tras someterse a análisis. A pesar de estos números, no se han confirmado muertes por las infecciones.
Todo se habría desatado por la fuga de un gas residual, proveniente de una fábrica de productos famacéuticos biológicos. Según Global Times, la empresa habría usado desinfectantes vencidos para producir una vacuna contra la Brucella.
El gas habría llegado a un instituto de investigación veterinaria, donde quedaron infectadas más de 180 personas. Luego habría alcanzado ciudades cercanas, como algunas de la provincia de Heilongjiang.
La Organización Mundial de la Salud indica que la brucelosis “es una enfermedad bacteriana causada por varias especies de Brucella, que infectan principalmente al ganado vacuno, porcino, caprino y ovino y a los perros. Los humanos generalmente contraen la enfermedad por contacto directo con animales infectados, por comer o beber productos animales contaminados o por inhalar agentes transmitidos por el aire. La mayoría de los casos se producen por la ingestión de leche o queso no pasteurizados de cabras u ovejas infectadas”.
Y agrega: “La brucelosis es una de las zoonosis más extendidas transmitidas por los animales y, en las zonas donde es endémica, la brucelosis humana tiene graves consecuencias para la salud pública”.